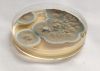
DCP_0104.jpg
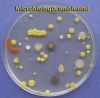
DCP_2011.JPG

Curso 2007-08 |
 |
| TÍTULO |
+ |
- |
| NOME DO ARQUIVO |
+ |
- |
| DATA |
+ |
- |
| POSICION |
+ |
- |
|
|

Illamento124 visualizacións
|
|

Cultivo puro49 visualizacións
|
|

Observación do crecemento81 visualizacións
|
|

Laboratorio de Microbioloxía73 visualizacións
|
|

Preparación de medios69 visualizacións
|
|

Inoculando unha placa72 visualizacións
|
|

Inoculando unha placa64 visualizacións
|
|

Bacterias anaeróbicas65 visualizacións
|
|

Contador de colonias64 visualizacións
|
|
Pecnicillium sobre agar62 visualizacións
|
|
Placa exposta ó aire logo de ser incubada65 visualizacións
|
|

Dpto. de Ciclos Formativos94 visualizacións
|
|
| 54 arquivos de 5 páxina(s) |
 |
1 |  |
 |
 |
 |
|
